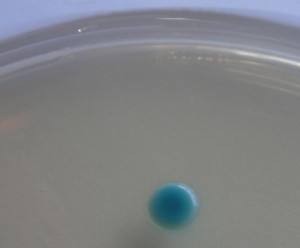
Candida Cromokit

CANDIDA CROMOGENIC AGAR es un medio selectivo y cromogénico para la detección y diferenciación de especies Candida con importancia clínica y cosmética. C.albicans: colonias verde-azuladas
COMPOSICIÓN
Peptona 10,0 g
Glucosa 20,0 g
Cloranfenicol 0,50 g
Mezcla cromogénica 0,40 g
Agar-Agar 15,0 g
(Fórmula por litro) pH final : 6,1 ± 0,2
PREPARACIÓN
Disolver 46 gramos in1 l de agua destilada.Calentar hasta el punto de ebullición. No autoclavar!!! No sobrecalentar! El color final del medio es crema-ámbar.
PARA USO EXCLUSIVO EN LABORATORIO. AGITE EL BOTE ANTES DE USAR, PARA ASEGURAR LA HOMOGENEIZACIÓN DE LOS EVENTUALES GRADIENTES DE DENSIDAD DE LOS COMPONENTES. MANTENGA EL BOTE BIEN CERRADO EN LUGAR SECO, FRESCO Y OSCURO.
DESHIDRATADO CODIGO: DMT321
CONTROL DE CALIDAD DEL MEDIO:
Realizado en nuestro laboratorio; es prudente repetirlo en su laboratorio siempre que varíen las condiciones (más de 3 meses sin usar, tras desinfectar laboratorio, tras conservar a alta Tª, cuando adquiere aspectos extraños aunque no haya llegado la fecha de caducidad teórica de la etiqueta,…).
DESHIDRATADO: Polvo grueso, Crema . PREPARADO: Estéril, Crema
CONTROL DE CRECIMIENTO 24-72 h a 30-37°C aproximadamente:
Candida albicans MKTA 10321, Excelente, colonias verde-azul celeste.
C. tropicalis MKTA 1369, Excelente, colonias azul oscuro-añil-violeta.
Candida krusei MKTA 34135, Excelente, colonias rosas-púrpura.
C. parapsilopsis MKTA 22019, Excelente, colonias blancas-púrpura.
>Candida glabrata MKTA 2001, Excelente, colonias blancas-púrpura.
PRESENTACIÓN: MEDIO DESHIDRATADO.
SIEMBRA E INTERPRETACIÓN
Sembrar en superficie, en estría, a partir del exudado (o bien, en cosmética, a partir del caldo enriquecido LPT Neutralizing Broth DMT217).
Incubar 24-72 horas a 30-37°C.
Observar la aparición de colonias verde-azuladas (C.albicans), azul-violáceas (C.tropicalis) o rosadas (C.krusei, C.parapsilopsis, C.glabrata).
NOTA
Las diferentes especies infecciosas de Candida deben ser distinguidas rápidamente para que el tratamiento sea más efectivo, ya que la más común de ellas, C.albicans, es susceptible a los medicamentos con azol, mientras las demás son resistentes a los mismos. La diferenciación de las tres especies (C.albicans, C.krusei y C.tropicalis) mediante el color de sus colonias, gracias a la mezcla cromogénica, en la reacción de la hexosaminidasa o de la fosfatasa alcalina, y en sólo 24 horas, es un importante avance en microbiología clínica.
El usuario es el único responsable de la eliminación de los microorganismos según la legislación medioambiental vigente. Autoclavar antes de desechar a la basura.
Si desea más información sobre nuestro MEDIO CANDIDA CROMOKIT AGAR rellene nuestro formulario de contacto http://www.medioscultivo.com/contacto o contacte a través de nuestro correo electrónico microkit@microkit.es o teléfono en el nº 91-897 46 16.
https://www.microkit.es/fichas/CROMOKIT-Medios-cromogenicos-MICROKIT.pdf
Prepárese para más de una sorpresa informativa cuando vea nuestro video sobre los medios Cromogénicos: https://www.youtube.com/watch?v=-JVPVWxY8ZE&t=271s